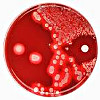

Для уточнения цены и услуги выберите подраздел в начале страницы.
Запись
1020₽
+7(499 ..показать +7(499) 11-68-239
MedSwiss на проспекте Обуховской Обороны Санкт-Петербург; пр-т Обуховской Обороны, д. 120Б ; м. Пролетарская
Запись
1080₽
+7(495 ..показать +7(499) 11-68-239+7(495) 987-91-05 +7(495) 623-53-72 +7(495) 987-97-37
Медицинский центр Минфина России Москва; ул. Ильинка, д. 9, стр. 1 ; м. Китай-Город
Запись
1300₽
+7(499 ..показать +7(499) 11-68-239
СМТ на Римского-Корсакова Санкт-Петербург; пр-т Римского-Корсакова, д. 87 ; м. Садовая
Запись
1300₽
+7(383 ..показать +7(499) 11-68-239+7(383) 362-02-00 +7(965) 827-82-69 +7(383) 388-84-72 +7(961) 879-57-27
МЦ Здравица на 1905 года Новосибирск; ул. 1905 года, д. 73 ; м. Красный проспект
Запись
1300₽
+7(383 ..показать +7(499) 11-68-239+7(383) 362-02-00 +7(965) 827-82-69 +7(383) 388-84-72 +7(961) 879-57-27
МЦ Здравица на Дуси Ковальчук Новосибирск; ул. Дуси Ковальчук, д. 272/1 ; м. Заельцовская
Запись
1300₽
+7(383 ..показать +7(499) 11-68-239+7(383) 362-02-00 +7(965) 827-82-69
МЦ Здравица на Шевченко Новосибирск; ул. Шевченко, д. 31А ; м. Октябрьская
Запись
1300₽
+7(383 ..показать +7(499) 11-68-239+7(383) 362-02-00 +7(965) 827-82-69 +7(383) 388-84-72 +7(961) 879-57-27
МЦ Здравица на площади Карла Маркса Новосибирск; пл. Карла Маркса, д. 7 ; м. Площадь Карла Маркса
Запись
1300₽
+7(383 ..показать +7(499) 11-68-239+7(383) 389-54-91
Клиника НИИТО на Фрунзе 19А Новосибирск; ул. Фрунзе, д. 19А ; м. Красный проспект
Запись
1300₽
+7(383 ..показать +7(499) 11-68-239+7(383) 362-02-00 +7(965) 827-82-69 +7(383) 388-84-72 +7(961) 879-57-27
МЦ Здравица на Державина Новосибирск; ул. Державина, д. 28 ; м. Сибирская
Запись
1320₽
+7(383 ..показать +7(499) 11-68-239+7(383) 363-06-31 +7(383) 218-59-29
Алмита на Железнодорожной Новосибирск; ул. Железнодорожная, д. 12/1 ; м. Красный проспект
Запись
1510₽
+7(844 ..показать +7(499) 11-68-239+7(844) 259-10-12
Диалайн на бульваре Энгельса Волгоград; б-р Энгельса, д. 27Б ;
Запись
1540₽
+7(812 ..показать +7(499) 11-68-239+7(812) 561-45-68
XXI век на Ленской Санкт-Петербург; ул. Ленская, д. 17, корп. 1 ; м. Проспект Большевиков
Запись
1600₽
+7(383 ..показать +7(499) 11-68-239+7(383) 312-01-22
Клиника Медпрактика на Красина Новосибирск; ул. Красина, д. 68 ; м. Березовая роща
Запись
1600₽
+7(383 ..показать +7(499) 11-68-239+7(383) 332-05-51
Медсанчасть №168 на Арбузова 6 Новосибирск; ул. Арбузова, д. 6 ; м. Студенческая
Запись
1600₽
+7(383 ..показать +7(499) 11-68-239+7(383) 332-05-51
Медсанчасть №168 на Академика Коптюга Новосибирск; ул. Академика Коптюга, д. 13 ; м. Студенческая
Запись
1790₽
+7(383 ..показать +7(499) 11-68-239+7(383) 363-01-83
ЦНМТ на проспекте Академика Коптюга Новосибирск; пр-т Академика Коптюга, д. 13 ; м. Речной вокзал
Запись
1790₽
+7(383 ..показать +7(499) 11-68-239+7(383) 363-01-83
ЦНМТ на Титова Новосибирск; ул. Титова, д. 7 ; м. Площадь Карла Маркса
Запись
2100₽
+7(495 ..показать +7(499) 11-68-239+7(495) 150-57-26 +7(925) 122-22-95
МЦ Stepmedicals на Касаткина Москва; ул. Касаткина, д. 3 ; м. ВДНХ
Запись
2500₽
+7(495 ..показать +7(499) 11-68-239+7(495) 646-05-66 +7(916) 564-86-36
МедиДент в Королёве Королёв; Октябрьский бульвар, д. 5 ;
Запись
5000₽
+7(921 ..показать +7(499) 11-68-239+7(921) 764-42-92
Клиника доктора Гамидова на Парадной Санкт-Петербург; ул. Парадная, д. 3, корп. 2 ; м. Чернышевская
Ещё клиник - 1324 . Используйте фильтры